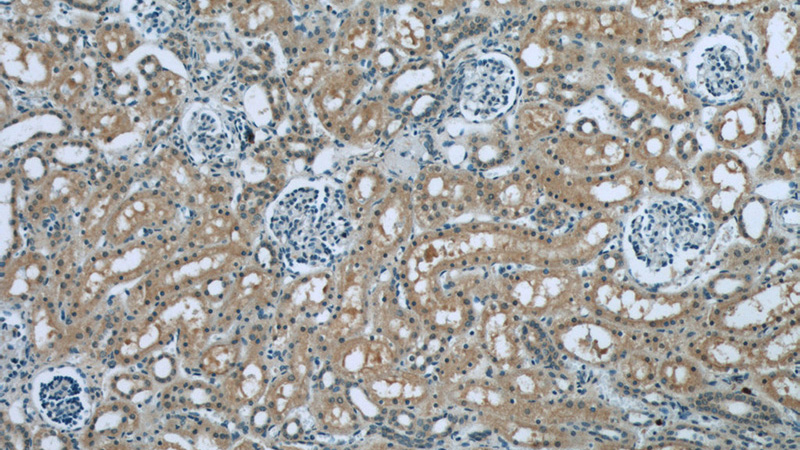
Immunohistochemistry of paraffin-embedded human kidney tissue slide using Catalog No:114845(RPS6KA3 Antibody) at dilution of 1:50(under 10x lens)
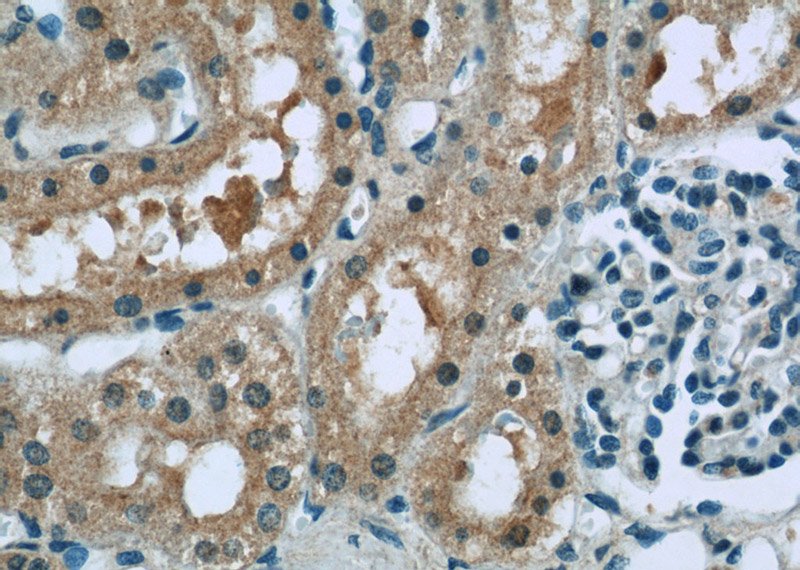
Immunohistochemistry of paraffin-embedded human kidney tissue slide using Catalog No:114845(RPS6KA3 Antibody) at dilution of 1:50(under 40x lens)

-
Product Name
RSK2 antibody
- Documents
-
Description
RSK2 Rabbit Polyclonal antibody. Positive IP detected in K-562 cells. Positive WB detected in K-562 cells, HepG2 cells, MCF7 cells, mouse heart tissue, NIH/3T3 cells. Positive IF detected in HepG2 cells, HUVEC cells. Positive IHC detected in human kidney tissue. Observed molecular weight by Western-blot: 84 kDa
-
Tested applications
ELISA, WB, IHC, IF, IP
-
Species reactivity
Human, Mouse; other species not tested.
-
Alternative names
CLS antibody; HU 3 antibody; ISPK 1 antibody; ISPK1 antibody; MAPKAP kinase 1b antibody; MAPKAPK 1b antibody; MAPKAPK1B antibody; MRX19 antibody; p90 RSK 3 antibody; p90 RSK2 antibody; p90RSK3 antibody; pp90RSK2 antibody; Ribosomal S6 kinase 2 antibody; RPS6KA3 antibody; RSK antibody; RSK 2 antibody; RSK2 antibody; S6K alpha 3 antibody; S6K alpha3 antibody
- Immunogen
-
Isotype
Rabbit IgG
-
Preparation
This antibody was obtained by immunization of RSK2 recombinant protein (Accession Number: NM_004586). Purification method: Antigen Affinity purified.
-
Clonality
Polyclonal
-
Formulation
PBS with 0.02% sodium azide and 50% glycerol pH 7.3.
-
Storage instructions
Store at -20℃. DO NOT ALIQUOT
-
Applications
Recommended Dilution:
WB: 1:500-1:5000
IP: 1:500-1:5000
IHC: 1:20-1:200
IF: 1:10-1:100
-
Validations

K-562 cells were subjected to SDS PAGE followed by western blot with Catalog No:114845(RPS6KA3 antibody) at dilution of 1:1000

IP Result of anti-RPS6KA3 (IP:Catalog No:114845, 4ug; Detection:Catalog No:114845 1:1000) with K-562 cells lysate 4000ug.
Immunohistochemistry of paraffin-embedded human kidney tissue slide using Catalog No:114845(RPS6KA3 Antibody) at dilution of 1:50(under 10x lens)
Immunohistochemistry of paraffin-embedded human kidney tissue slide using Catalog No:114845(RPS6KA3 Antibody) at dilution of 1:50(under 40x lens)

Immunofluorescent analysis of HepG2 cells using Catalog No:114845(RPS6KA3 Antibody) at dilution of 1:25 and Rhodamine-Goat anti-Rabbit IgG
-
Background
RPS6KA3(Ribosomal protein S6 kinase alpha-3) is also named as ISPK1, MAPKAPK1B, RSK2 and belongs to the protein kinase superfamily. It localizes at the kinetochores under spindle checkpoint conditions, and during mitosis, associated with the centrosomes, the spindle and at the mid-body(PMID:20383198). It is required for epidermal growth factor activated phosphorylation of histone H3, which may cause chromatin remodeling and facilitate gene transcription and maybe playing an essential regulatory role in protein synthesis during cell proliferation.
Related Products / Services
Please note: All products are "FOR RESEARCH USE ONLY AND ARE NOT INTENDED FOR DIAGNOSTIC OR THERAPEUTIC USE"
